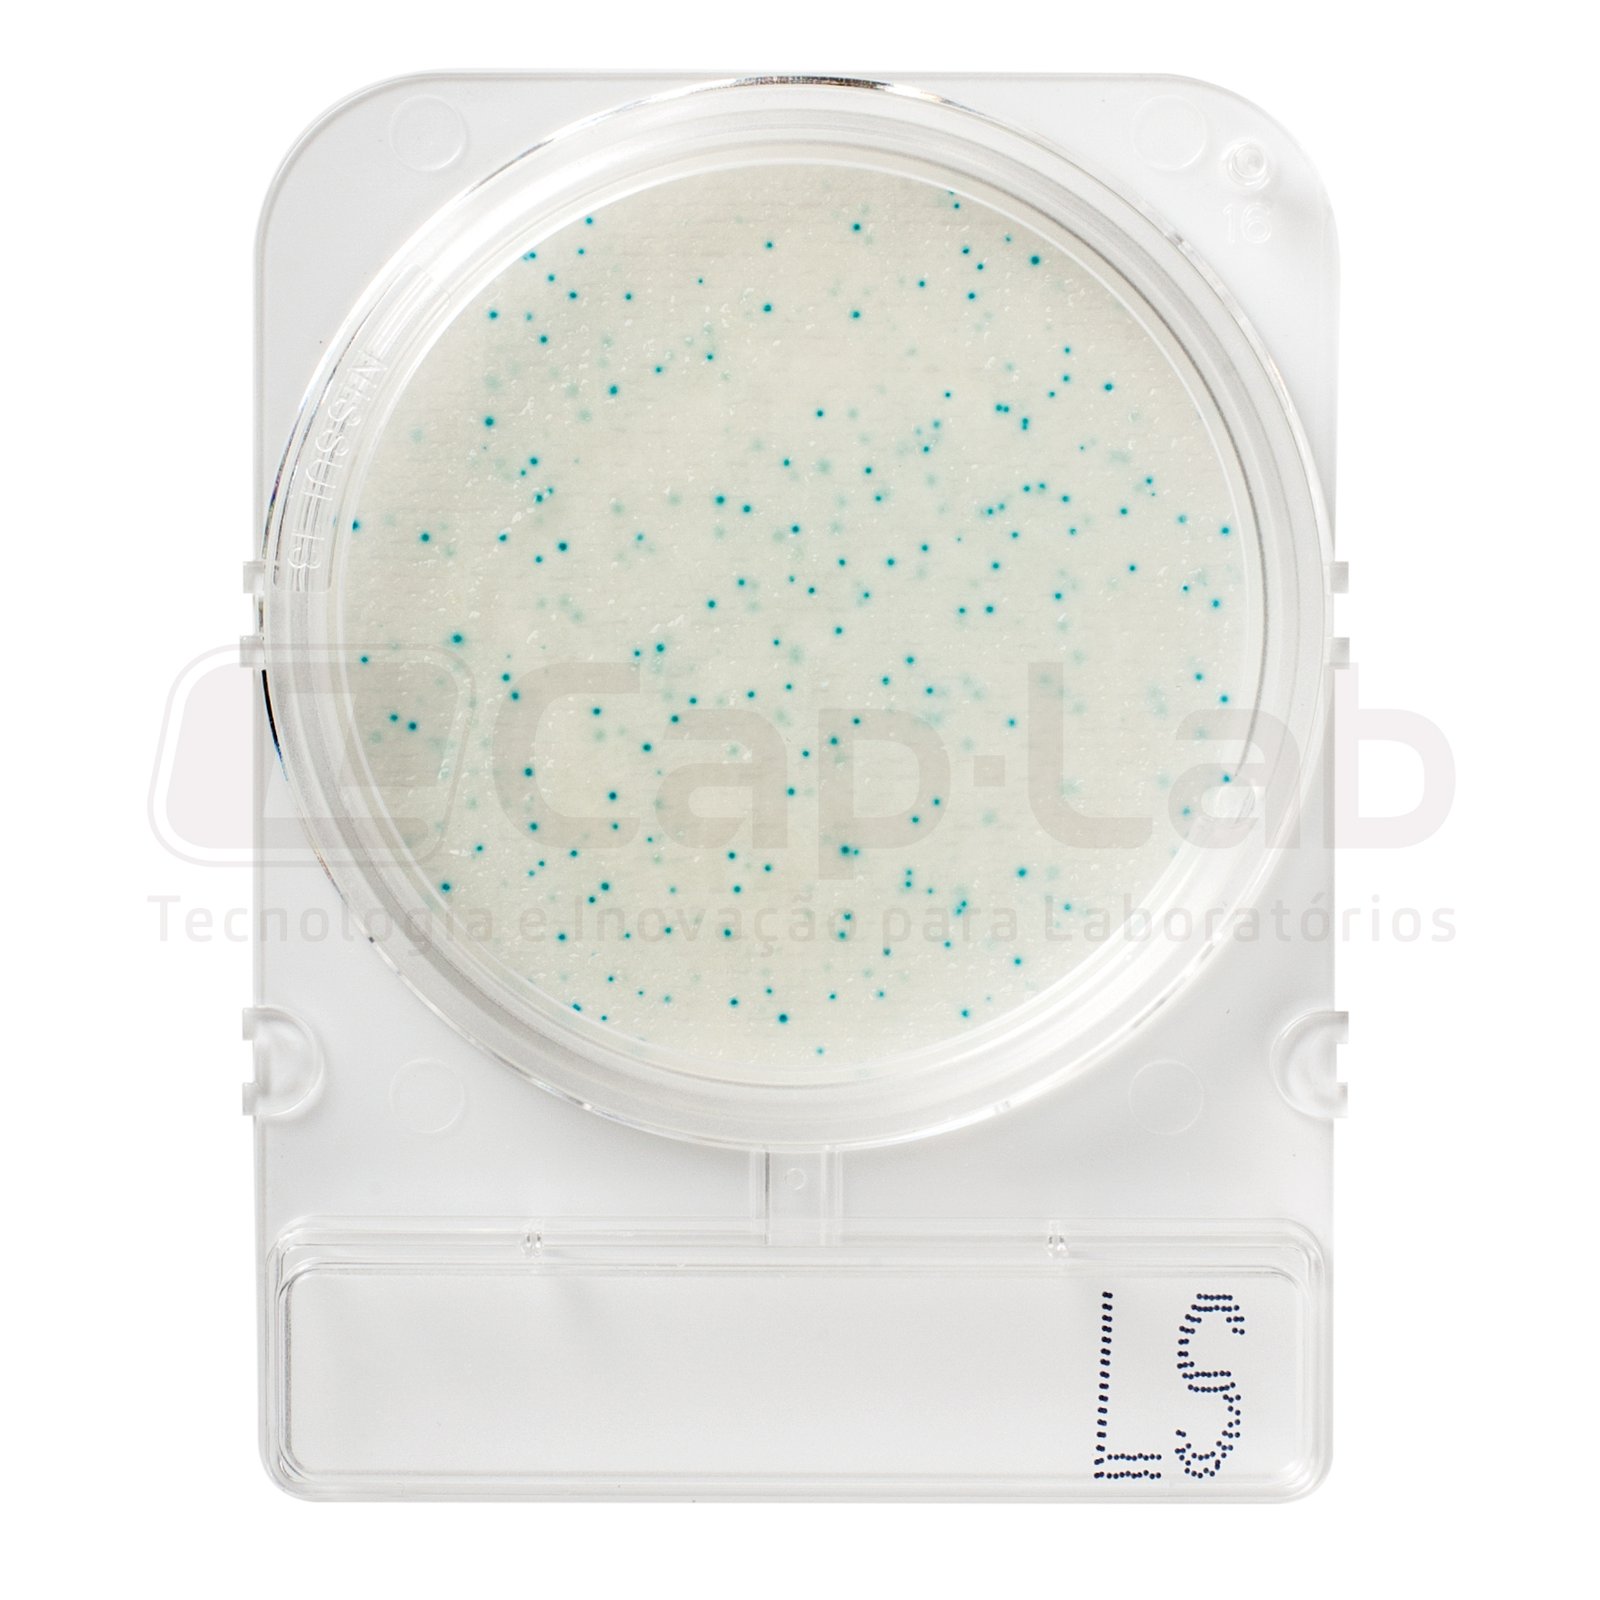

Compact Dry LS
Listeria spp
Incubação: 24h
Temperatura: 37 ± 1°C
Descrição:
Listeria é um gênero de bactérias bacilares, Gram-positivas, anaeróbias facultativas, flagelados, ubíquas (encontradas no solo, na água e em animais) e que não produzem esporos.
Elas estão associadas à dupla importância clínica à sua atividade de virulência. Mas entre as seis espécies de Listeria existentes, a mais prevalente é a L. monocitogenes, causando listeriose, incluindo meningite por sepse, encefalite, úlcera de córnea, pneumonia, infecção cervical e aborto, onde idosos, imunocomprometidos, mulheres grávidas e bebês são os mais afetados.
Devido ao aumento do surto de contaminação por Listeria, alguns alimentos de alto risco são os seguintes: frutos do mar, frutas pré-embaladas, legumes, drink feito de frutas, delicatessen, carnes, leite cru, sorvetes, queijos, molhos para salada e guarnições de vegetais crus.
Procedimento
Qualitativa
- Adicionar 25 gramas ou 25 mL de amostra ao saco stomacher, ou frasco de diluição;
- Adicionar 225mL de diluente caldo Half – Fraser e homogeneizar;
- Incubar a 30 ± 1°C por 24 horas;
- Após esse intervalo de tempo, remover a tampa da Compact dry LS, coletar 1,0 mL da amostra enriquecida e inocular no centro da placa;
- Tampe a placa novamente. A amostra espalha-se automaticamente e transforma a folha seca em gel em poucos segundos;
- Inverter e incubar a 37 ± 1°C por 24-48h;
- Leitura do resultado.
Quantitativa
- Adicionar 25 gramas ou 25 mL de amostra ao saco stomacher, ou frasco de diluição;
- Adicionar 225mL de diluente água peptonada tamponada e homogeneizar;
- Manter o frasco tampado contendo a amostra em repouso por 1 hora a 30°C ;
- Após esse intervalo de tempo, remover a tampa da Compact dry LS, na placa inocular 1 ml de água destilada esterilizada e coletar 0,1ml da amostra enriquecida e inocular formando estrias.
- Tampe a placa novamente. A amostra espalha-se automaticamente e transforma a folha seca em gel em poucos segundos;
- Inverter e incubar a 37 ± 1°C por 24-48h;
- Leitura do resultado.
Interpretação de resultados:
Colônias azuis ou azuis claras de cerca de 1-2 mm de diâmetro.